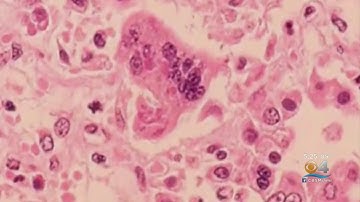
New Record Number Of Measles

⬇ DOWNLOAD NOW
Kalau muncul iklan pop-up, tutup lalu klik tombol kembali
Download lagu Record number of measles cases secara gratis hanya untuk keperluan promosi. Dukung artis favorit kamu dengan membeli musik original di iTunes atau platform resmi lainnya.
New Record Number Of Measles
New Record Number Of Measles
 Measles outbreak hits record high since elimination in 2000
Measles outbreak hits record high since elimination in 2000
 Measles Cases Reach Record Numbers
Measles Cases Reach Record Numbers
 U.S. records highest number of measles cases since 1992, CDC says
U.S. records highest number of measles cases since 1992, CDC says
 Measles cases hit 33-year high in U.S.: What's happening?
Measles cases hit 33-year high in U.S.: What's happening?
 Measles Cases Reach Record High Since 2000
Measles Cases Reach Record High Since 2000
 Measles Cases Hit Record High Since U S Eliminated Disease
Measles Cases Hit Record High Since U S Eliminated Disease
 Kyle measles case highlights who might need an MMR vaccine
Kyle measles case highlights who might need an MMR vaccine